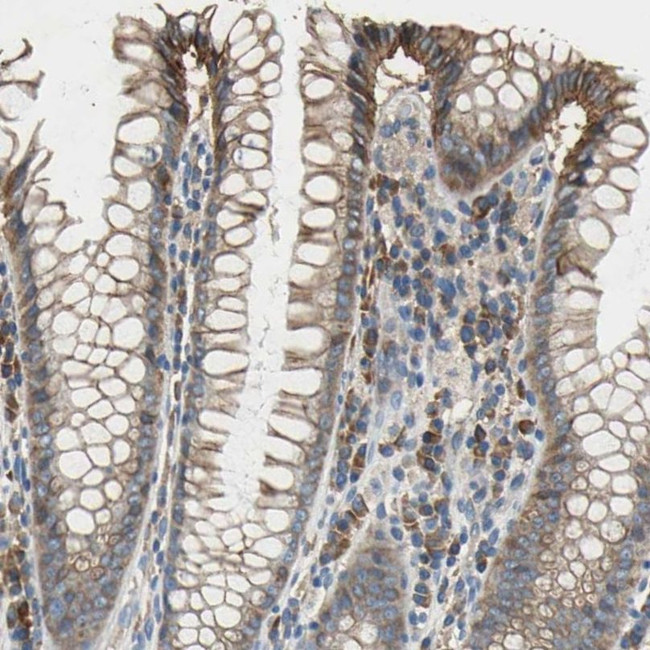
HEPH Antibody in Immunohistochemistry (IHC)

Search
Invitrogen
HEPH Polyclonal Antibody
{{$productOrderCtrl.translations['antibody.pdp.commerceCard.promotion.promotions']}}
{{$productOrderCtrl.translations['antibody.pdp.commerceCard.promotion.viewpromo']}}
{{$productOrderCtrl.translations['antibody.pdp.commerceCard.promotion.promocode']}}: {{promo.promoCode}} {{promo.promoTitle}} {{promo.promoDescription}}. {{$productOrderCtrl.translations['antibody.pdp.commerceCard.promotion.learnmore']}}

Please note: We are reviewing Western blot images included in the antibody testing data in our catalog, including those provided by third parties. Unless expressly labeled or annotated as “raw-unedited”, Western blot images included in the antibody testing data in our catalog may have been edited, optimized or otherwise adjusted for presentation.
产品信息
PA5-52214
种属反应
宿主/亚型
分类
类型
抗原
偶联物
形式
浓度
规格
纯化类型
保存液
内含物
保存条件
运输条件
RRID
产品详细信息
Immunogen sequence: QLQGMRKGAA MLFPHTFVMA IMQPDNLGTF EIYCQAGSHR EAGMRAIYNV SQCPGHQATP RQRYQAARIY YIMAEEVEWD YCPDRSWERE WHNQSEKDSY GYIFLSNKDG LLGSRYKKAV FREYTDGTFR IPRPRTGPEE HLGILGPLI
Highest antigen sequence identity to the following orthologs: Mouse - 87%, Rat - 86%.
靶标信息
B1AJX8(HEPH) is similar to an iron transport protein found in mouse. The mouse protein is similar to ceruloplasmin, a serum multi-copper ferroxidase, and is thought to be a membrane-bound protein responsible for transport of dietary iron from epithelial cells of the intestinal lumen into the circulatory system. In mouse, defects in this gene can lead to severe microcytic anemia. Three transcript variants encoding different isoforms have been described for this gene. The protein encoded by this gene is similar to an iron transport protein found in mouse. The mouse protein is similar to ceruloplasmin, a serum multi-copper ferroxidase, and is thought to be a membrane-bound protein responsible for transport of dietary iron from epithelial cells of the intestinal lumen into the circulatory system. In mouse, defects in this gene can lead to severe microcytic anemia. Two transcript variants encoding different isoforms have been described for this gene.
仅用于科研。不用于诊断过程。未经明确授权不得转售。